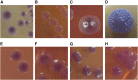

Presence of Burkholderia pseudomallei in Soil and Paddy Rice Water in a Rice Field in Northeast Thailand, but Not in Air and Rainwater
- PMID: 29016340
- PMCID: PMC5805070
- DOI: 10.4269/ajtmh.17-0515
Presence of Burkholderia pseudomallei in Soil and Paddy Rice Water in a Rice Field in Northeast Thailand, but Not in Air and Rainwater
Abstract
Environmental Burkholderia pseudomallei has been postulated to be aerosolized during ploughing and heavy rain, and could result in inhalational melioidosis. Here, we determined the presence of B. pseudomallei in soil, paddy field water (PFW), air, and rainwater samples in a single rice paddy field in Ubon Ratchathani, northeast Thailand. In 2012, we collected 100 soil samples during the dry season, 10 PFW samples during the monsoon season, 77 air samples during ploughing (N = 31) and heavy rains (N = 46), and 60 rainwater samples during 12 rain events. We found that 32 soil samples (32%), six PFW samples (60%), and none of the air and rainwater samples were culture positive for B. pseudomallei. Other soil bacteria were isolated from air and rainwater samples. Mean quantitative count of B. pseudomallei estimated from two culture-positive PFW samples was 200 colony forming units/mL. Our findings suggest that the risk of melioidosis acquisition by inhalation in Thailand might be low.
Figures

References
-
- Limmathurotsakul D, et al. 2016. Predicted global distribution of Burkholderia pseudomallei and burden of melioidosis. Nat Microbiol 1: 15008. - PubMed
-
- White NJ, Dance DA, Chaowagul W, Wattanagoon Y, Wuthiekanun V, Pitakwatchara N, 1989. Halving of mortality of severe melioidosis by ceftazidime. Lancet 2: 697–701. - PubMed
MeSH terms
LinkOut - more resources
Full Text Sources
Other Literature Sources

